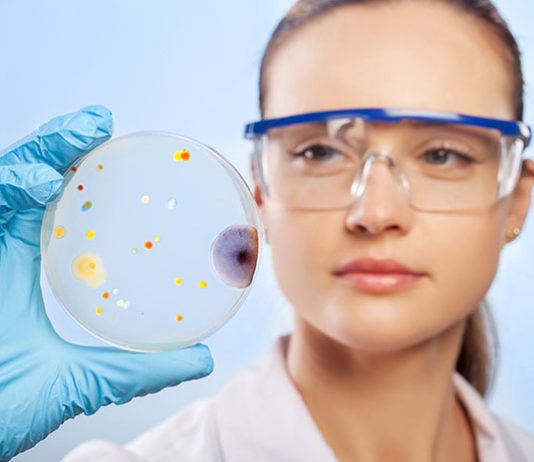
Kiedy kobieta może oddać komórkę jajową Kiedy kobieta może oddać komórkę jajową

Laparoskopia – metoda diagnostyczna i lecznicza
Laparoskopia to obecnie jedna z najczęściej stosowanych metod do przeprowadzania rozmaitych zabiegów operacyjnych oraz badań diagnostycznych. Swą popularność zawdzięcza przede wszystkim dużej skuteczności połączonej...
Dokładne oczyszczanie skóry w domu
Aby uzyskać piękną i zdrową cerę konieczne jest jej codzienne prawidłowe oczyszczanie. Warto dowiedzieć się o nowych produktach, które umożliwiają efektywne usunięcie martwych komórek...
Jak wygląda profilaktyka zatruć podczas wyjazdu za granicę?
Wymarzony wyjazd do krajów tropikalnych nie zawsze jednak wygląda tak, jak planowaliśmy. „Klątwa Faraona”, „galop gringo” - w zależności od części świata inaczej się...
Ból w okolicy pępka – jaka może być przyczyna
Ucisk brzucha, to należy przyznać, iż pojęcie nie konkretne, bo ucisk może wybierać się w dalekich częściach brzucha, na przykład w nadburzuszu, podbrzuszu, śródbrzuszu,...
NA CZYM POLEGA DIETA ENDOMORFIKA?
Dietetycy dzielą różne sylwetki na trzy podstawowe typy – mezomorficzną, ektomorficzną i endomorficzną.
*Osoby z sylwetką mezomorficzną nawet przy nie dużym treningu wyglądają bardzo dobrze....
Olimp L-karnityna 500 forte plus – opinie, skład, działanie
L-Karnityna 500 Forte Plus to suplement diety zawierający w swoim składzie L-karnityną, wzbogaconą L-Argininą, L-L-ornityną oraz chromem. Preparat przeznaczony jest dla osób dorosłych, które...
Fenomen kroplówek witaminowych
W ostatnim czasie panuje moda na kuracje witaminowe w formie kroplówek. Dożylna suplementacja witaminami po raz pierwszy pojawiła się w Azji i błyskawicznie rozpowszechniła...
Czy ciastka bez cukru to dobry pomysł podczas diety?
Ci, którzy przechodzą na dietę, często mówią, że to właśnie słodyczy brakuje im najbardziej. Gdy jednak zależy nam na zrzuceniu nadmiaru kilogramów oraz wyrzeźbieniu...
Ciemieniucha – czym jest i jak ją zlikwidować?
Ciemieniucha nie jest groźna i występuje u większości, jak nie u wszystkich niemowląt. Jest to dziecięca forma łojotokowego zapalenia skóry pojawiającego się kilka dni...
Nawracające hemoroidy – zobacz, jak im zapobiegać
Hemoroidy – czyli guzki krwawnicze – to naturalna część anatomiczna odbytu, którego zadaniem jest kontrolowanie oddawania gazów i stolca. Niekiedy jednak na skutek różnych...